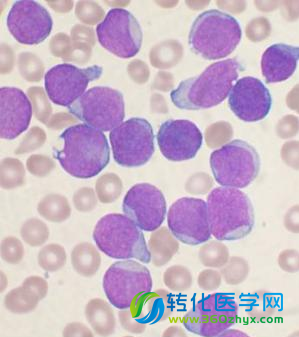
癌细胞也能被“策反” 可将白血病细胞转化为免疫细胞

四篇Nature子刊:人类基因组可以去掉一千个
Nature Genetics杂志三月二十五日连发四篇文章,展示了在同一个人群中进行的最大规模全基因组测序。冰岛deCODE公司的这个庞大测序项目不仅揭示了新的疾病风险基因和人类进化线索,还在人类基因组中鉴定了一千个似乎无关紧要的基因。 DeCODE全基因组研究是“一项壮举,”麻省总医院的人类遗传学家Daniel MacArthur评论道。“这在五...
Development cell:应用CRIS
近日,来自美国哈佛大学的研究人员在国际学术期刊Development cell发表了他们的最新研究进展,他们利用基于CRISPR-Cas9技术开发的载体系统在斑马鱼上实现了组织特异性基因敲除,这对于以斑马鱼为主要研究工具的科学家们无疑是一个好消息。
华中农业大学Nature子刊发表测序新成果
来自华中农业大学、明尼苏达大学的研究人员开发出一种简单的方法从玉米四分体(tetrad)分离出4个小孢子,并对单个小孢子进行了全基因组测序,在单细胞水平上剖析了减数分裂重组。这一重要的研究成果发表在3月24日的《自然通讯》(Nature Communications)杂志上。
eLife:科学家通过“哄骗”干细胞使其形成3
近日,一项发表于国际杂志eLife上的研究论文中,来自密歇根大学医学院的研究人员通过研究诱导干细胞使其成功分化为三维迷你型的肺部组织,此前研究中研究者研究者主要是利用在捐赠的器官上生长扁平细胞系统及细胞来衍生出肺部组织。
科学家利用DNA测序技术追踪耐多药结核病的传播
近期,一项发表于国际杂志Emerg Infect Dis上的研究论文中,来自伦敦大学的研究人员通过研究首次利用DNA测序技术来追踪英国结核病人多重抗药性结核病的传播扩散情况; TB(结核分枝杆菌)的传播扩散是通过吸入感染者散播在空气中的飞沫而致,TB可以长期生活在个体的肺部中而不产生任何症状,这个阶段就称为潜伏感染期。
Sci Transl Med :促进心脏组织再
哺乳动物的心脏组织在受到损伤比如心脏病发作后会失去再生的能力,这部分是由于重新激活心肌细胞和增殖程序的能力发生了缺失。近日,发表在国际著名杂志Science Translational Medicine上的一篇研究论文中,来自宾夕法尼亚大学的研究人员的研究人员通过研究发现,在成年哺乳动物中存在较低水平的心肌细胞会发生增殖。
Neuron:基因改变如何造成家族性阿尔茨海默
在早老蛋白1基因中的突变,是造成遗传性,早发性阿尔茨海默氏病最常见的原因。在一项在《Neuron》杂志上的新研究中,科学家使用造成阿尔茨海默氏病的人基因形式替换了正常的小鼠的早老蛋白1基因,来研究这些基因变化可能是如何导致的混乱。他们令人惊讶的结果可能会转变科学家设计靶向这些突变的药物的方式,而这些药物是用来治疗遗传性或者家族性的阿尔茨海默氏病的,该种疾病是一种罕见的,影响大约1%的人的疾病。该研究获得了神经疾病与中风国家研究所(NINDS)的资助,其是美国国立卫生研究院的一部分。
GOTTCHA:性能卓越的宏基因组分析工具
随着测序技术的发展,宏基因组学逐渐成为了新的热门领域。宏基因组学主要是鉴定环境样本中的所有微生物,理解它们各自所起的作用。这类研究比一般的基因组分析更需要计算机技术的帮助,因为宏基因组学研究的是不同基 ...
Nature Cell Biology:高通量
人类肠道是一件了不起的事情。每周,肠道都会再生一层新的内皮细胞,脱落的表面面积相当于一个小型公寓,并用新的细胞进行修复。
聚焦:一触即发的CRISPR专利大战
基于CRISPR-Cas9 的基因组编辑技术正在给整个学术界和工业界带来革命性地变化。一场围绕CRISPR-Cas9的专利大战也随之打响了,两个团队分别号称自己最先发明了这项技术,双方各执一词,整个生物界莫衷一是。我们不妨 ...
中国首次发现致兔唇基因 或可帮助孕妇检测预防
清华大学与中国生物芯片工程中心等机构的科研人员,首次在遗传基因中发现一个可能导致中国人出现唇腭裂的重要位点。此前外国专家找到的位点,只对西方人种有致病可能。相关论文昨天在国际顶级学术期刊《自然通讯》发表。
新型国际计划“全球球蛋白2020年挑战”即将开
日前,人类基因变异组计划宣布他们将发起一项名为“全球球蛋白2020年挑战”(GG2020)的新型国际计划,旨在解决人类的遗传性血液障碍,研究者们已经在近日在马来西亚吉隆坡举办的人类基因组大会上宣布了这项研究计划。
澳政府将出资1900万美元用于人类疾病新疗法的
近日,澳大利亚政府表示,他们将计划奖励一个研究团体1910万美元,鼓励其进行基因组学研究来帮助开发预防、诊断及治疗疾病的新疗法。
NIH出资1400万美元用于建立新型生物样本库
Coriell研究所日前宣布,他们已经接受了来自美国国立卫生研究院1400万美元的竞争性资助,而这些资助是用来用来支持国立医学科学研究所(NIGMS)进行人类基因细胞库研究的。
癌细胞也能被“策反” 可将白血病细胞转化为免疫
当一群极具攻击性的白血病细胞在体内肆虐时,最好的解决方法不是杀灭而是对其进行转化和“策反”。日前,来自美国斯坦福大学医学院的一项研究让人耳目一新。研究人员称,该发现有望为白血病的治疗奠定下坚实的基础。相关论文3月16日在线发表在美国《国家科学院学报》网站上。
澳发明新基因测序技术“捕获测序”有助快速诊断血
澳大利亚科学家发明了一种新的基因测序技术,其精度大大高于现有方法。它就像一台倍数更高的显微镜,可用于对基因组进行精细研究,并帮助快速诊断血癌(即白血病)。
栏目推荐
| 代谢组学 | 肿瘤 |
| Nature子刊: |
| Cell | 华人 |
| 一文回顾 | 3月 |
| Nature:中心 |
 腾讯登录
腾讯登录